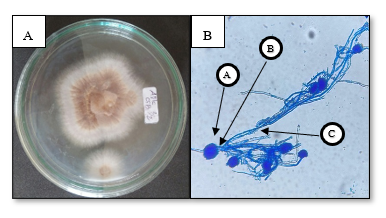

Trends
Sci.
2026; 23(2): 11378
Chemical Profiling and Evaluation of Antibacterial and Anticancer Potential of Endophytic Aspergillus Terreus GCD2 Isolated from Garcinia Cowa Roxb. ex Choisy: In Vitro and Silico Approaches
Muhammad Azhari Herli1,2,4, Putri Ulinza1, Netti Suharti5,
Djong Hong Tjong3 and Dian Handayani1,*
1Laboratory of Sumatran Biota/Faculty of Pharmacy, Universitas Andalas, Kampus Limau Manis, Padang, Indonesia
2Department of Biomedical Science, Faculty of Medicine, Universitas Andalas, Padang, Indonesia
3Department of Biology, Faculty of Mathematics and Natural Sciences, Universitas Andalas, Padang, Indonesia
4Departement of Pharmacy, Faculty of Mathematics and Natural Sciences, Universitas Muhammadiyah Riau,
Riau, Indonesia
5Department of Microbiology, Faculty of Medicine, Universitas Andalas, Padang, Indonesia
(*Corresponding author’s e-mail: [email protected])
Received: 25 July 2025, Revised: 13 August 2025, Accepted: 23 August 2025, Published: 20 November 2025
Abstract
Garcinia cowa Roxb. ex Choisy, a medicinal plant rich in bioactive secondary metabolites, has long been used in traditional medicine for its diverse therapeutic properties. Endophytic fungi associated with medicinal plants have emerged as promising sources of pharmacologically active compounds with antibacterial and anticancer potential in recent years. This study investigates an endophytic fungus isolated from G. cowa leaves, identified as Aspergillus terreus GCD2 (93.56% BLAST score) through macroscopic, microscopic, and molecular characterization. Crude extracts of GCD2, obtained using ethyl acetate, were profiled via LC-MS/MS, revealing Aurasperone B and Fonsecinone B as the predominant secondary metabolites. Antibacterial activity, evaluated using the Kirby-Bauer diffusion method, showed inhibition against methicillin-resistant Staphylococcus aureus (MRSA) with a zone diameter of 12.44 mm. Cytotoxicity testing demonstrated potent bioactivity, with LC₅₀ and IC₅₀ values of 79.45 μg/mL (Brine Shrimp Lethality Test) and 14.45 μg/mL (MTT assay on MCF-7 breast cancer cells), respectively. Molecular docking simulations indicated strong binding affinities of Aurasperone B and Fonsecinone B to MRSA and breast cancer-related receptors. Against MRSA, both compounds interacted with Asn120 adjacent to the canonical binding site, yielding docking scores of –7.11 and –7.09 kcal/mol (RMSD_refine 0.98 Å and 0.91 Å). Against breast cancer receptors, they bound to Arg146 and Tyr202, with docking scores of –6.00 and –6.20 kcal/mol (RMSD_refine 1.28 Å and 1.32 Å). These findings highlight A. terreus GCD2 as a promising source of antibacterial and anticancer agents. Further research focusing on compound isolation, mechanistic studies, and in vivo validation is warranted to advance its pharmaceutical potential.
Keywords: Garcinia cowa Roxb. ex Choisy, Aspergillus terreus, Endophytic fungi, Antibacterial, Cytotoxicity, Molecular docking, Aurasperone B, Fonsecinone B
Garcinia cowa Roxb. ex Choisy, locally known as asam kandis, is a medium-sized evergreen tree naturally distributed across several Asian countries, including Nepal, East India (Assam, Bengal, Bihar, Mizoram, and Orissa), Cambodia, Laos, Malaysia, Myanmar, Thailand, Vietnam, and Indonesia. This plant’s distinctive morphological and phytochemical characteristics contribute to its extensive use in traditional medicine. Phytochemical analyses have revealed that G. cowa contains diverse bioactive compounds, including despidones, flavonoids, phenolglucinols, terpenes, steroids, and xanthones [1-3].
Scientific investigations have confirmed the medicinal potential of G. cowa, attributing its therapeutic effects to its richness in secondary metabolites such as flavonoids, terpenoids, phenolics, and steroidal compounds. With the increasing demand for safer and more sustainable therapeutic agents, plant-derived natural products are gaining recognition as promising alternatives to synthetic drugs. However, their integration into modern therapeutic applications requires rigorous scientific validation to ensure efficacy, safety, and sustainability. Comprehensive toxicological, pharmacological, and conservation studies are essential to regulate and optimize their medicinal use. G. cowa has been reported to exhibit a broad spectrum of biological activities, including antimicrobial, anti-inflammatory, antioxidant, antimutagenic, antiplatelet, anticancer, and antidiabetic effects. Compared to synthetic agents, plant-based extracts often offer advantages regarding biocompatibility and environmental safety. Consequently, the bioactive secondary metabolites of G. cowa continue to attract considerable interest in natural product research, particularly for their potential applications in drug discovery and ethnopharmacology [4-7].
In recent years, there has been a notable shift from relying solely on medicinal plants to exploring microorganisms, particularly microbes and microbiomes, as alternative and promising sources of secondary metabolites. This paradigm shift has fueled interest in endophytic fungi-microorganisms that inhabit the internal tissues of plants without causing apparent harm to their hosts. Endophytic fungi have garnered significant attention due to their ability to synthesize a broad spectrum of bioactive compounds with potential applications in medicine, agriculture, and biotechnology. These symbiotic organisms contribute to plant health by promoting growth, enhancing resistance to biotic and abiotic stress, and producing metabolites that may mimic or surpass those of their host plants. Notably, endophytic fungi are prolific producers of structurally diverse and pharmacologically significant secondary metabolites, such as anthraquinones, sesquiterpenoids, and cyclic peptides, many of which exhibit potent antibacterial, antifungal, and anticancer activities [8,9]. Their metabolic versatility makes them a valuable resource for drug discovery and developing novel therapeutic agents. Accordingly, investigating endophytic fungi from medicinal plants offers a sustainable and environmentally friendly route to identifying novel metabolites with therapeutic potential.
Endophytic fungi isolated from G. cowa have demonstrated promising antibacterial activity, particularly against common and drug-resistant bacterial strains. These microorganisms produce a wide array of bioactive secondary metabolites capable of inhibiting bacterial growth. A previous study successfully isolated 13 endophytic fungal strains from G. cowa, among which the GCA3 isolate, identified as Penicillium citrinum, exhibited notable antibacterial activity, with inhibition zones of 15.05 ± 0.51 mm against Staphylococcus aureus, 14.68 ± 0.50 mm against Escherichia coli, and 13.48 ± 0.15 mm against methicillin-resistant Staphylococcus aureus (MRSA) [10]. The antibacterial properties of these endophytes are primarily attributed to their ability to synthesize potent antimicrobial metabolites, which are influenced by the host plant species and their growth media—an important factor in addressing the global challenge of multidrug-resistant pathogens [9]. In addition to antibacterial activity, bioactive compounds from endophytic fungi associated with G. cowa have shown anticancer potential. However, these compounds remain insufficiently characterized. This aligns with broader findings that endophytic fungi can produce structurally diverse molecules with efficacy against various bacterial species and cancer cell lines [11].
Despite the reported bioactivities of G. cowa-associated endophytes, there is still limited research on the comprehensive characterization of their bioactive metabolites, particularly those with dual antibacterial and anticancer potential. Moreover, studies integrating chemical profiling, biological evaluation, and molecular docking to elucidate possible mechanisms of action remain scarce. The present study investigates an endophytic fungus isolated from G. cowa leaves, identified as Aspergillus terreus GCD2, to address this gap. The study aims to (i) characterize its secondary metabolites using LC-MS/MS, (ii) evaluate its antibacterial activity against MRSA, (iii) assess its cytotoxic effects through Brine Shrimp Lethality Test (BSLT) and [3-(4,5-Dimethylthiazol-2-yl)-2,5-Diphenyltetrazolium Bromide] (MTT) assays, and (iv) explore molecular interactions of its key metabolites with antibacterial and anticancer target proteins through docking simulations. The findings are expected to contribute to discovering novel bioactive compounds from endophytic fungi and support their potential development as sustainable therapeutic agents.
Materials and methods
Sample materials
The materials used in this study consisted of 13 ethyl acetate extracts of endophytic fungi isolated from G. cowa Roxb. ex Choisy (asam kandis) plants, obtained from previous studies [10].
Methods
Brine shrimp lethality test (BSLT)
The Brine Shrimp Lethality Test (BSLT) is a widely used preliminary bioassay for evaluating the general toxicity of natural product extracts and screening for bioactive compounds. Artemia salina L. (family: Artemiidae) nauplii were used in this assay. Brine shrimp eggs were incubated in 500 mL of filtered seawater under continuous aeration for 48 h at 27 ± 2 °C to allow hatching. Post-hatching, active nauplii were collected and distributed into experimental vials. Each test group contained ten nauplii exposed to varying concentrations of the GCD2 fungal extract (1,000, 500, 100, 50, and 10 μg/mL) dissolved in dimethyl sulfoxide (DMSO). The negative control group received only DMSO in sterile seawater. After 24 h of incubation at room temperature, mortality was recorded, and the median lethal concentration (LC₅₀) was calculated using probit analysis based on the mortality data [12,13].
Cell culture and MTT cytotoxicity assay
The MTT assay was performed to evaluate the cytotoxic effects of the ethyl acetate fraction of the GCD2 fungal extract on MCF-7 human breast cancer cells, following the procedure described by Kumar et al. [14] and Meerloo et al. [15]. MCF-7 cells were obtained from the Cancer Chemoprevention Research Center (CCRC), Faculty of Pharmacy, Gadjah Mada University, and cultured in Dulbecco’s Modified Eagle Medium (DMEM) supplemented with 10% fetal bovine serum (FBS) and 1% penicillin–streptomycin. Cells were seeded in 96-well plates at a density of 6 × 10³ cells/well in 100 μL of medium and incubated overnight at 37 °C in a humidified atmosphere containing 5% CO₂.
A stock solution of the fungal extract was prepared in dimethyl sulfoxide (DMSO) at 100,000 ppm. After 24 h, the culture medium was removed, and cells were washed with sterile phosphate-buffered saline (PBS). Subsequently, 100 μL of treatment solution (100 ppm extract in medium) was added to each well. The experimental design included treatment groups, a positive control (Paclitaxel), a cell control (untreated cells), and a media control (blank). Following treatment, plates were incubated for 24 h under the same conditions. Cell viability was determined by adding MTT solution, incubating, and measuring absorbance at 540 nm using an ELISA microplate reader. The absorbance values were used to calculate the percentage of viable cells, measuring the extract’s cytotoxicity [14,15]. % Cell viability is calculated by the equation [15,16].

Determination of IC₅₀ value
The cytotoxicity of the fungal extracts was further quantified by determining the half-maximal inhibitory concentration (IC₅₀) using the same MTT assay protocol described for sample screening. The ethyl acetate extract of the GCD2 fungus was tested at concentrations of 500, 250, 125, 62.5 and 31.25 ppm. Paclitaxel was the positive control and tested at concentrations of 100, 50, 10, and 5 ppm. The IC₅₀ value was calculated from the dose–response curve by plotting the percentage of cell viability against the logarithmic concentration of the sample. The resulting curve was analyzed to determine the concentration at which cell viability was reduced by 50% [15,16].
Statistical methods
To determine the IC₅₀ values, the natural logarithm of the sample concentrations (ln [concentration]) was regressed against the corresponding percentage of cell viability. The resulting regression equation was used to estimate the IC₅₀, defined as the concentration at which cell viability was reduced by 50%. Alternatively, IC₅₀ values were also calculated using probit analysis with statistical software (SPSS) to provide more precise interpolation [15,16].
LC-MS/MS analysis of endophytic fungi extracts GCD2
The bioactive extract of GCD2 fungi that showed good antibacterial and cytotoxic activity was then analysed using a Liquid Chromatography-Mass Spectrometry (LC-MS/MS) instrument with UPLCQToF-MS/MS (Ultra Performance Liquid Chromatography-Quadrupole Time of Flight-Mass Spectrometry) specifications to determine the compounds contained. Liquid chromatography-tandem mass spectrometry is an analytical technique that combines liquid chromatography as a component separator in a sample with mass spectrometry as a detector. This study used a tandem mass spectrometry-based tool, MassLynx version 4.1 [17]. MassLynx version 4.1 is the default software for the Water LC-MS/MS tool, a widely used software for processing and interpreting mass spectrometry data to identify phytochemicals. It can read raw data from the water LCMS/MS results in MS1 and MS2, which are then searched for compound annotation in an online database. Compound annotation utilised online databases such as MassBank (https://massbank.eu/MassBank/), the Human Metabolome Database (HMDB, https://www.hmdb.ca/), and ChemSpider (https://www.chemspider.com/), with ion fragmentation pattern matching used to distinguish compounds with similar m/z values. The ionisation process was conducted at 2 energy levels: Low energy (4 V) to detect precursor ions and high energy (25 - 60 V) to obtain fragment (daughter) ions. When searching for compounds by molecular formula, a hydrogen atom (1.00782 Da) was subtracted to account for protonation during ionisation, resulting in a positively charged molecular ion [18-20].
Morphology and molecular identification of endophytic fungi
The morphological identification of the purified endophytic fungal isolate was initially conducted based on macroscopic and microscopic characteristics. Macroscopic features such as colony color, texture, margin, and growth rate were observed on Sabouraud Dextrose Agar (SDA) after incubation at room temperature (25 C) for 5 - 7 days. Microscopic examination was performed by preparing slide cultures stained with lactophenol cotton blue and observing the hyphal structure, conidiophores, vesicles, and spore morphology under a light microscope. Genomic DNA was extracted for molecular identification, and the internal transcribed spacer (ITS) region of ribosomal RNA was amplified using universal fungal primers. The ITS region comprises 4 parts: The large subunit rRNA, ITS1, 5.8S rRNA, and ITS2. The amplification and sequencing procedures followed the methodology described by Sandrawati et al. [11]. This work was conducted collaboratively between Genetica Science Indonesia (Tangerang, Banten) and the Environmental Biotechnology Laboratory (EBL) of the Indonesian Center for Biodiversity and Biotechnology (ICBB), Bogor, West Java, reflecting a joint commitment to robust and accurate species identification.
PCR products were sequenced by First BASE Laboratories (Malaysia), using high-throughput sequencing technology to ensure data quality and reliability. The resulting sequences were analyzed using the BLAST tool (https://blast.ncbi.nlm.nih.gov/Blast.cgi) to compare with sequences in the NCBI GenBank database. Species identification was performed based on the closest sequence similarity, following the approach described by Tallei and Kolondam. [21]. A phylogenetic tree was constructed using the neighbor-joining method with 1,000 bootstrap replications to confirm taxonomic placement. MEGA software (https://www.megasoftware.net/dload_win_beta) [22] was used to generate the tree and evaluate genetic relationships among related fungal species. The fungal isolate GCD2 was identified as Aspergillus terreus based on morphological features and ITS sequence homology.
Molecular docking analysis
The bioactive compounds identified through LC-MS/MS analysis were evaluated using molecular docking simulations with the Molecular Operating Environment (MOE) 2024.06 software. The MRSA receptor and breast cancer receptor were selected from the RCSB Protein Data Bank (https://www.rcsb.org/). MOE was used for docking simulations to determine how well the compounds could bind to the active site's MRSA receptor (PDB ID: 6Q9N) and breast cancer receptor (PDB ID: 6O0K) [23-26]. The basis for conducting molecular docking simulations on MRSA receptors is the inhibitory power of ethyl acetate extract from the endophytic fungus GCD2, as reported in previous research on MRSA, which was 12.44 mm [10]. Meanwhile, docking simulations using breast cancer receptors are based on examination results using BSLT (shown in Table 1) and MTT Test data IC50 in this research (IC50 value of the ethyl acetate extract of the endophytic fungi A. terreus (GCD2) is 14.45 μg/mL).
Molecular docking simulation begins with preparing the target protein, followed by preparing test ligands and native ligands. The docking process involves the interaction of test ligands and native ligands with the receptor's active site. The final stage consists of validating the molecular docking process and interpreting the results [27]. The target receptor was prepared in MOE using a quick preparation method, which aims to optimise the receptor structure by correcting the protonation and optimising the receptor's charge. Ligand testing in the preparation seeks to optimise the ligand energy with the MMFF94X force field, correcting the ligand charge and ligand structure to obtain an optimal ligand structure ready for molecular docking simulations. In the docking procedure, a range of binding modes was generated, and the one with the least binding energy, emphasising kcal/mol, was chosen as the most optimal [28]. Visualisation of ligand binding with receptors in 2D and 3D molecular docking results using BIOVIA Discovery Studio Visualizer software (https://discover.3ds.com/discovery-studio-visualizer-download) [29].
Results and discussion
Medicinal plants have long been recognized for their health benefits and have been widely used in traditional medicine for centuries. Today, they are often utilized in the form of extracts, valued for their therapeutic efficacy and relatively low side effects. However, the limited production of secondary metabolites in native medicinal plants can restrict access to their bioactive compounds. Over time, the overharvesting of these plants can also lead to the gradual depletion of their natural resources. Endophytes, which include bacteria, fungi, algae, and actinobacteria, are microorganisms that live inside plants without causing visible symptoms. They have been detected in all plant species, suggesting an ancient and co-evolved relationship between plants and their endophytes. This association is mutually beneficial: the host plant provides nutrients and shelter, while the endophytes enhance the host’s resilience against biotic and abiotic stresses. Among endophytes, fungi are fascinating due to their ability to produce diverse bioactive molecules, often mirroring those their host plants synthesize. This biochemical similarity suggests that endophytic fungi can serve as alternative and sustainable sources of pharmacologically active secondary metabolites. Numerous studies have reported that endophytic fungi isolated from medicinal plants can produce compounds with therapeutic properties equivalent to those of their hosts, offering potential in drug discovery and natural product development [8,30-32].
The findings of this study reinforce the view that endophytic fungi are a promising alternative source for discovering new therapeutic agents. This work forms part of an ongoing effort to identify bioactive compounds from endophytic fungi isolated from diverse sources, including marine sponges, mangrove trees, and medicinal plants from West Sumatra, Indonesia [10,11,33,34]. Extensive research has also examined the chemical composition and biological activities of various parts of G. cowa Roxb. ex Choisy. Previous investigations on its fresh leaves, fruits, and dried bark have revealed that the main constituents are organic acids and their lactones, which contribute significantly to its pharmacological properties [3,5,6].
Screening of antibacterial activity, based on the results of previous studies [10], and cytotoxicity of endophytic fungal extracts derived from G. cowa Roxb. ex Choisy (asam kandis) were evaluated using the agar diffusion method and the Brine Shrimp Lethality Test (BSLT), respectively. The results are summarized in Table 1.
Table 1 Antibacterial activity and toxicity screening (BSLT) of endophytic fungal extracts from G. cowa Roxb. ex Choisy.
Fungal code |
Organ |
Average of inhibition zone (mm) |
LC50 (ppm) |
||
S. aureus |
MRSA |
E. coli |
|||
GCA1 |
Root |
11.23 |
10.09 |
10.35 |
128.41 |
GCA2 |
Root |
11.9 |
11.67 |
11.13 |
89.09 |
GCA3 |
Root |
14.11 |
15.4 |
15.22 |
370.06 |
GCB1 |
Stem |
10.37 |
11.25 |
9.5 |
190.12 |
GCB2 |
Stem |
9.91 |
12.1 |
10.06 |
97.47 |
GCB3 |
Stem |
7.42 |
8.93 |
7.73 |
147.59 |
GCB4 |
Stem |
11.6 |
12.95 |
12.2 |
257.8 |
GCD1 |
Leaf |
- |
- |
- |
4.87 |
GCD2 |
Leaf |
22.72 |
12.44 |
11.521 |
79.45 |
GCD3 |
Leaf |
11.43 |
11.04 |
7.39 |
191.43 |
GCD4 |
Leaf |
- |
- |
- |
319.06 |
GCD5 |
Leaf |
8.09 |
8.73 |
8.13 |
83.19 |
GCD6 |
Leaf |
8.55 |
8.68 |
8.64 |
89.29 |
Positive Control |
- |
30.22 |
30.19 |
30.59 |
- |
Positive control: Oxoid® disks containing 30 µg/mL chloramphenicol
Among the thirteen extracts tested, several exhibited notable antibacterial activity accompanied by varying degrees of cytotoxicity, as indicated by their LC₅₀ values. The ethyl acetate extract GCD2 demonstrated the broadest antibacterial spectrum, significantly inhibiting S. aureus (22.72 ± 0.01 mm), E. coli (11.521 ± 0.002 mm), and MRSA (12.44 ± 0.02 mm). It also showed appreciable cytotoxicity, with an LC₅₀ value of 79.45 μg/mL, suggesting its potential as a bioactive candidate for pharmaceutical development. In contrast, extract GCD1 displayed the lowest LC₅₀ value, indicating higher cytotoxicity, but lacked measurable antibacterial activity.
Based on these results, GCD2 was selected for further investigation, including cytotoxicity testing against MCF-7 breast cancer cells, chemical profiling using LC-MS/MS, and molecular docking analysis of its active compounds with antibacterial and anticancer target proteins. Overall, extracts GCA3, GCD1, and GCD2 emerged as promising candidates due to their antibacterial efficacy and acceptable cytotoxicity profiles. Notably, GCD2’s selective potency, including activity against resistant Gram-negative bacteria, highlights its potential as a valuable source for developing novel antibacterial agents.
Molecular identification and morphology of endophytic fungi GCD2
The endophytic fungus GCD2, isolated from the leaf of the asam kandis plant (G. cowa Roxb. ex Choisy), was identified using macroscopic and microscopic examinations. On Sabouraud Dextrose Agar (SDA) medium, GCD2 colonies appeared cream to brown, often with clumps exhibiting yellow pigmentation. Microscopic observation using a Binocular TCLG microscope revealed distinctive morphological features compared with standard fungal identification keys and literature. GCD2 displayed compact, columnar conidial heads measuring up to 500 μm in length with a diameter of 30 - 50 μm [35,36]. The conidiophores bore hyaline, smooth-walled, spherical conidia with diameters of 1.5 - 2.5 μm (Figure 1). Molecular identification was conducted by sequencing the internal transcribed spacer (ITS) region, a widely recognized molecular barcode for fungi due to its high interspecific variability and strong discriminatory power at both genus and species levels. BLAST analysis revealed a 93.56% sequence similarity to Aspergillus terreus, confirming the taxonomic identity of GCD2 (Figure 2).
Note: a. Conidia, b. Fialid, c. Conidiophores
Figure 1 Macroscopic (A) and microscopic (B) pictures of fungal isolate GCD2.

Figure 2 DNA sequence at the ITS region of the endophytic fungi isolated from the asam kandis (G. cowa Roxb. ex Choisy) Plant was aligned by the MEGA software.
Phylogenetic analysis based on ITS region sequences
A phylogenetic analysis was performed using the neighbor-joining method in MEGA software, based on ITS region sequences and comparison with the NCBI database (https://blast.ncbi.nlm.nih.gov/Blast.cgi). The phylogenetic tree was constructed to determine the genetic relationship between the endophytic fungus GCD2 (Aspergillus terreus) and other related endophytic fungal species [37]. As shown in Figure 3, GCD2 clusters closely with A. terreus and Aspergillus sp., indicating a closer genetic relationship with these species than with A. neoindicus or A. carneus.

Figure 3 Phylogenetic Tree of endophytic fungi GCD2.
Toxicity and cytotoxicity test
BSLT and MTT assay
The Brine Shrimp Lethality Test (BSLT) results showed that the LC₅₀ values of the ethyl acetate extracts from the fungal isolates ranged from 1 to 335 ppm. According to Lestari et al. [38], plant or animal extracts are classified as cytotoxic if the LC₅₀ value is < 1,000 ppm. Specifically, extracts with LC₅₀ < 30 ppm are considered highly toxic, 30 - 1,000 ppm are considered toxic, and > 1,000 ppm are considered non-toxic. For pure compounds, an LC50< 200 ppm is regarded as toxic. Based on this classification, the ethyl acetate extract of endophytic fungus GCD2, with an LC₅₀ of 79.45 μg/mL, falls within the toxic category and warrants further investigation for potential anticancer compounds.
The BSLT has been reported to correlate reasonably well with cytotoxic activity against certain human solid tumors and has contributed to the discovery of promising new classes of antitumor agents. The LC₅₀ value of 79.45 μg/mL obtained for GCD2 indicates toxicity to the test organism (Artemia salina larvae), suggesting the potential for toxic effects in humans, particularly at high doses. However, determining its safety for human use will require further toxicity evaluations, including both in vitro and in vivo studies in appropriate animal models, followed by clinical assessments. Cytotoxic agents can disrupt fundamental cellular processes, including growth, mitosis, differentiation, and function. The observed cytotoxic activity of the ethyl acetate extract in this study may be attributed to one or more of these mechanisms. Further cytotoxicity evaluation was performed using the microtetrazolium (MTT) assay against MCF-7 human breast cancer cells, obtained from the CCRC Laboratory, Faculty of Pharmacy, Universitas Gadjah Mada. This colorimetric assay measures cell viability based on mitochondrial enzyme activity and allows determination of the half-maximal inhibitory concentration (IC₅₀), defined as the concentration of the extract or compound that inhibits 50% of cell viability [14,15].
The extract was tested at concentrations of 500, 250, 125, 62.5 and 31.25 μg/mL, each in triplicate. Initial screening indicated that the ethyl acetate extract of GCD2 produced the lowest cell viability (≤ 50%) against MCF-7 cells at a concentration of 31.25 μg/mL. IC₅₀ determination was subsequently performed on this extract using linear regression analysis of the dose–response curve, yielding an IC₅₀ value of 14.45 μg/mL. For comparison, the positive control, Paclitaxel, exhibited an IC₅₀ of 11.09 μg/mL. According to the National Cancer Institute (NCI) and the classification by Niksic et al. [39], compounds with IC₅₀ ≤ 20 μg/mL are considered highly cytotoxic, 21 - 200 μg/mL moderately cytotoxic, 201 - 500 μg/mL weakly cytotoxic, and > 500 μg/mL inactive. Based on these criteria, the ethyl acetate extract of A. terreus (GCD2) demonstrates highly cytotoxic activity against MCF-7 cells, positioning it near the threshold of this category.
In this preliminary study, we report a significant finding: the secondary metabolites present in the fungal extract exhibit potent cytotoxic activity. This result is highly valuable, as it provides a strong basis for future research aimed at isolating and structurally characterizing cytotoxic compounds from the endophytic fungus A. terreus GCD2. The demonstrated potential of this extract as a source of novel drug candidates for cancer treatment highlights its importance and underscores the relevance of continuing investigations into its bioactive constituents.
Identification of secondary metabolite content
The fungal extract of GCD2 was analyzed using Liquid Chromatography-Tandem Mass Spectrometry (LC-MS/MS) equipped with an Ultra-Performance Liquid Chromatography–Quadrupole Time-of-Flight Mass Spectrometer (UPLC-QToF-MS/MS). This high-resolution analytical technique was employed to identify bioactive secondary metabolites potentially responsible for the extract's cytotoxic activity. The sensitivity and mass accuracy of UPLC-QToF-MS/MS enable precise detection and structural characterization of various compound classes, including phenolics, flavonoids, alkaloids, and terpenoids, many of which are associated with anticancer properties [11,18].
Mass spectrometry data were acquired and processed using MassLynx™ software, which generated chromatograms and MS spectra for molecular weight determination and formula prediction. Compound identification was achieved by matching the observed molecular formulas and fragmentation patterns with those available in public MS databases, including MassBank, the Human Metabolome Database (HMDB), and ChemSpider. To ensure accurate compound annotation, MS/MS spectra were compared with reference fragmentation data, accounting that isobaric compounds may share similar m/z values but differ in fragmentation behavior. The MS system was operated in dual-energy mode: low collision energy (4 V) was used to detect intact parent ions ([M + H]⁺), while high collision energy (25 - 60 V) was applied to generate daughter ions for structural elucidation. Protonation during electrospray ionization was considered by subtracting 1.00782 Da from the [M + H]+ ion, ensuring accurate molecular mass calculations [19,20].
LC-MS/MS analysis of the ethyl acetate extract from the endophytic fungus A. terreus GCD2 generated a chromatogram with several prominent peaks at distinct retention times (Figure 4). These data were used to identify secondary metabolites present in the extract. Six bioactive compounds were detected, representing naphthopyran, benzophenone, chromone, cyclic peptide, and phenol groups (Table 2). Among these, Aurasperone A exhibited the highest peak intensity in the chromatogram, indicating it as the major constituent. Aurasperone A, a dimeric naphthopyran, has been previously reported to possess various biological activities, including cytotoxic and antimicrobial properties [40,41]. Its abundance in the extract suggests a possible contribution to the observed cytotoxic activity against MCF-7 breast cancer cells, although further mechanistic investigations are required to confirm this role.

Figure 4 LC-MS/MS chromatogram of the ethyl acetate extract from the endophytic fungus A. terreus GCD2.
Table 3 Chemical composition of the ethyl acetate extract from the endophytic fungus A. terreus GCD2, identified by LC-MS/MS in positive ion mode, including compound names, chemical classes, retention times, and peak intensities.
Compound’s name |
Molecular formula |
Mass |
RT (mins) |
Parent on (m/z) |
Dulcioic acid [42] |
C7H12O8 |
224.165 g/mol |
5.19 |
224.0566 |
8-Benzyl-3-(4-biphenylyl)-4,9-dimethyl-7H-furo[2,3-f]chromen-7-one [43] |
C32H24O3 |
456.541 g/mol |
9.63 |
457.1761 |
Malformin [44] |
C23H39N5O5S2 |
529.7 g/mol |
10.46 |
530.249 |
Aurasperone B [45] |
C32H30O12 |
606.6 g/mol |
10.63 |
607.1821 |
Fonsecinone B [46] |
C32H28O11 |
588.6 g/mol |
11.30 |
589.1708 |
Aurasperone A [47] |
C32H26O10 |
570.550 g/mol |
12.57 |
571.1611 |
Molecular docking simulation
To explore its therapeutic relevance, molecular docking simulations were performed to assess the binding affinity and interaction profiles of six bioactive compounds with two types of target proteins, as shown in Tables 4 and 5. The first molecular docking simulation to determine the interaction between the ligand structure and the MRSA receptor, using the crystal structure of PBP2a MRSA (PDB ID: 6Q9N), which is part of the mecA gene, was performed with a resolution of 2.50 Å. This structure consists of 2 main chains, namely chain A and chain B, with a sequence length of 642 amino acids. This structure has 3 ligands: QLN, JPP, and MUR. The active binding site is on chain A at the XYZ centre coordinates –17.749267; –25.286833; 69.861767 with a radius of 10.034159 [25,26].
In the second molecular docking simulation to determine the interaction between the ligand structure and the breast cancer (BCL-2) receptor, the crystal structure of BCL-2 (PDB ID: 6O0K), which is involved in the apoptosis of cancer cells, was utilized, with a resolution of 1.62 Å. This structure consists of a single main chain, designated as chain A, with a sequence length of 166 amino acids. This structure has 2 ligands: LBM and 2PE. The active binding site is on chain A at the XYZ centre coordinates –15.323057; 2.213738; –9.593467 with a radius of 13.647127 [23,24].
As shown in Table 4, the native ligand of the MRSA receptor showed a binding score of –6.84 kcal/mol. In comparison, Aurasperone B and Fonsecinone B showed slightly lower scores of –7.11 kcal/mol and –7.09 kcal/mol, respectively, but Aurasperon A showed a slightly higher score of –5.67 kcal/mol. Aurasperone B (–7.11 kcal/mol) and Fonsecinone B (–7.09 kcal/mol) also showed slightly lower scores compared to the antibacterial drugs quinazolinone (–6.83 kcal/mol) and piperacillin (–6.95 kcal/mol) (Table 4). However, Aurasperone B and Fonsecinone B exhibit a more complex interaction pattern, featuring additional van der Waals and carbon-hydrogen interactions (Figure 5). For the bonding interaction between Aurasperone B and Fonsecinone B, when compared with the native ligand, there is the same bonding interaction with the amino acid residues at TYR 79, ILE 118, GLU 119, for hydrophobic interactions, as well as the amino acid residue ASN 120 specifically for hydrogen bonding interactions in Aurasperone B. Furthermore, Aurasperone B and Fonsecinone B exhibited a lower RMSD_refine value (0.98 Å and 0.91 Å) compared to the redocking native ligand (1.92 Å, Figure 5(D)), Quinazolinone (1.66 Å), and piperacillin (1.54 Å) (antibacterial drugs as control), suggesting a more stable docking pose with less deviation during refinement [48,49].
Table 4 Results of molecular docking simulations and Interactions with residue amino acid residues of MRSA Receptors (PDB ID: 6Q9N).
Protein Target |
Ligand |
S Value (kcal/mol) |
RMSD refine (Å) |
Interaction |
|
Hydrogen Interaction |
Hydrophobic Interaction |
||||
6Q9N |
Dulcic acid |
–4.71 |
1.31 |
- |
ASN 71, SER 72, TYR 105, ILE 144, GLU 145, ASN 146, ASN 204, TYR 297, SER 306, ASN 307, THR 308 |
8-Benzyl-3-(4-biphenylyl)-4,9-dimethyl-7H-furo[2,3-f]chromen-7-one |
–5.46 |
1.67 |
- |
ASN 71, SER 72, TYR 105, ILE 144, ASN 146, LYS 273, GLU 294,ASP 295, TYR 297, ASN 305, SER 306, ASN 307, THR 308, LYS 316 |
|
Aurasperone B |
–7.11 |
0.98 |
ASN 120, LYS 247 |
ASN 78, TYR 79, ILE 118, GLU 119, ASP 248, ASP 249, ASP 269, TYR 271, LYS 290, ASN 923 |
|
Malformin |
–6.45 |
1.68 |
CYS 2, TYR 79 |
- |
|
Fonsecinone B |
–7.09 |
0.91 |
LYS 247, ASP 249, LYS 290 |
TYR 79, ILE 118, GLU 119, ASN 120, ASP 249, GLU 268, ASP 269, TYR 271 |
|
Aurasperone A |
–5.67 |
1.95 |
- |
SER 72, ASN 104, TYR 105, ASN 146, ASN 204, TRP 205, GLY 296, ASP 303, SER 306, ASN 307, THR 308, ILE 309 |
|
Native_Ligand 6Q9N |
–6.84 |
1.92 |
ASN 120 |
TYR 79, ILE 118, GLU 119, THR 184, PHE 185, ASN 923, THR 924, ILE 925 |
|
Quinazolinone
|
–6.83 |
1.66 |
ASN 120, THR 916 |
TYR 79, ILE 118, GLU 119, HIS 759, GLU 761, VAL 918, ASN 923, THR 924, ILE 925 |
|
Piperacillin
|
–6.95 |
1.54 |
SER 46, ASN 78, TYR 79 |
||
*Residues in bold and underlined indicate the active site residues of the target protein.

Figure 5 Molecular interaction of the best compounds and antibacterial drugs with essential amino acid residues of the MRSA Receptor (PDB ID : 6Q9N). (A) Native Ligand (B) Fonsecinone B, (C) Aurasperone B, and (D) Redocking Native_ligand (RMSD: 1.92 Å).
In Table 5, the native ligand of the BCL-2 receptor shows a binding score of –11.40 kcal/mol. Aurasperone A, Aurasperone B, and Fonsecinone B show higher scores, respectively, –6.20 and –6.00 kcal/mol (Table 5). When compared with obatoxlac, which is an Anti-cancer drug with a binding score of –5.17 kcal/mol, the binding values of Aurasperone A, Aurasperone B, Fonsecinone B, and 8-Benzyl-3-(4-biphenylyl)-4,9-dimethyl-7H-furo[2,3-f]chromen-7-one are slightly lower and richer in Van der Waals bonds, hydrogen bonds, and π bonds.
For the bonding interaction of Fonsecinone B compared with the native ligand, there is the same bonding interaction with the amino acid residues at ALA 100, ARG 107, TYR 108, ARG 146, ALA 149, for hydrophobic interactions, as well as the amino acid residue TYR 202 specifically for hydrogen bonding interactions in Fonsecinone B. Furthermore, Aurasperone A, Aurasperone B, Fonsecinone B, and 8-Benzyl-3-(4-biphenylyl)-4,9-dimethyl-7H-furo[2,3-f]chromen-7-one exhibited a lower RMSD_refine value (2.10 Å, 1.28 Å, 1.32 Å, and 1.64 Å ) compared to the native ligand and obatoclax (2.14 Å and 2.12 Å), suggesting a more stable docking pose [48].
Table 5 Results of Molecular Docking Simulations and Interactions with residue Amino Acid Residues of Breast Cancer receptors (PDB ID: 6O0K).
*Residues in bold and underlined indicate the active site residues of the target protein.
The validity of the molecular docking process was assessed by calculating the root mean square deviation (RMSD) of the redocked native ligand relative to its initial (reference) position within the target protein. An RMSD value ≤ 2 Å is generally considered acceptable, indicating that the docked ligand’s position closely matches its original orientation [27,50,51]. In the 1st molecular docking simulation with the MRSA receptor, the RMSD for the redocked native ligand was 1.92 Å (Figure 5(D)). In the 2nd simulation with the BCL-2 receptor, the RMSD was 2.14 Å (Figure 6(E)). Both results fall within the acceptable threshold, confirming the reliability of the docking protocol.

Figure 6 Molecular interaction of the best compounds with essential amino acid residues of BCL-2 Receptor (PDB ID: 6o0k). ((A) Native Ligand, (B) Fonsecinone B, (C) Aurasperone B, (D) Obatoclax, and (E) Redocking Native_ligand (RMSD: 2.14 Å).
Conclusions
LC-MS/MS profiling of the endophytic fungus A. terreus GCD2, isolated from G. cowa Roxb. ex Choisy (Asam kandis) leaves, revealed Aurasperone B and Fonsecinone B as the dominant bioactive metabolites. The ethyl acetate extract exhibited notable cytotoxicity against A. salina larvae (LC₅₀ = 79.45 μg/mL) and potent inhibition of MCF-7 breast cancer cells (IC₅₀ = 14.45 μg/mL). Molecular docking suggested strong binding affinities of these compounds to MRSA and breast cancer-related receptors, supporting their potential as antibacterial and anticancer agents. However, these findings are limited to in vitro assays and computational predictions; the mechanisms of action remain to be fully elucidated. In vivo validation, toxicity profiling, and pharmacokinetic studies are crucial for assessing the therapeutic potential and safety of these compounds. Future work should focus on isolating and purifying these active compounds, confirming their bioactivities in animal models, and exploring the structure–activity relationships to optimize efficacy. Such efforts will be crucial to advancing A. terreus GCD2-derived metabolites toward pharmaceutical applications.
Ethics approval
This research protocol was evaluated by the Research Ethics Committee of the Faculty of Medicine, Andalas University, and received a positive assessment following a review of the study design, research protocol, and use of experimental animals. The ethical approval number is 133/UN.16.2/KEP-FK/2024.
Acknowledgements
This research was supported by the BOPTN Universitas Andalas, Riset Publikasi Terindeks (RPT) program, Indonesia, under contract number T/10/UN16.19/PT.01.03/KO-RPT/2023.
Declaration of Generative AI in Scientific Writing
The authors acknowledge the use of generative AI tools (e.g., QuillBot, Grammarly, and ChatGPT by OpenAI) in the preparation of this manuscript, specifically for language editing and grammar correction. No content generation or data interpretation was performed by AI. The authors take full responsibility for the content and conclusions of this work.
CRediT Author Statement
Muhammad Azhari Herli: Methodology; Investigation; Data curation; validation; Writing - Original draft; Visualization. Putri Ulinza: Investigation; Data curation; Validation. Netti Suharti: Supervision; Writing - Reviewing and Editing. Djong Hong Tjong: Supervision; Writing - Reviewing and Editing. Dian Handayani: Conceptualization; supervision; Methodology; Preparation; Data curation; validation; Writing - Reviewing and Editing.
References
[1] K Panthong, W Pongcharoen, S Phongpaichit and WC Taylor. Tetraoxygenated xanthones from the fruits of Garcinia cowa. Phytochemistry 2006; 67(10), 999-1004.
[2] T Ritthiwigrom, S Laphookhieo and SG Pyne. Chemical constituents and biological activities of Garcinia cowa Roxb. Maejo International Journal of Science and Technology 2013; 7(2), 212-231.
[3] K Panthong, N Hutadilok-Towatana and A Panthong. A new tetraoxygenated xanthone, and other anti-inflammatory and antioxidant compounds from Garcinia cowa. Canadian Journal of Chemistry 2009; 87(11), 1636-1640.
[4] A Sarma, P Sarmah, D Kashyap and A Kalita. Evaluation of nutraceutical properties and antioxidant activity of Garcinia cowa Roxb. ex Choisy fruits found in Assam (India). World Journal of Pharmacy and Pharmaceutical Sciences 2014; 3(12), 553-559.
[5] A Chouni and S Paul. A comprehensive review of the phytochemical and pharmacological potential of an evergreen plant, Garcinia cowa. Chemistry & Biodiversity 2023; 20(2), e202200910.
[6] NTK An, NV Hien, NT Thuy, DL Phuong, HG Bach, NT Tra, NQ Tung, PT Tham, BH Tai and TTT Thuy. Garcicowanones C-E, three new hydrated-geranylated xanthones from the roots of Garcinia cowa Roxb. ex Choisy, and their α-glucosidase inhibition activities. Natural Product Research 2023; 37(21), 3668-3676.
[7] HL Devi, B Das, T Angami and B Kandpal. Garcinia cowa Roxb. ex Choisy (Clusiaceae). In: AA Waman and P Bohra (Eds.). Perennial underutilized horticultural species of India. Jaya Publishing House, Delhi, India, 2021, p. 131-143.
[8] F Eshboev and D Egamberdieva. Medicinal plant-associated endophytic fungi: Metabolites and bioactivity. In: D Egamberdieva, JA Parray and K Davranov (Eds.). Plant endophytes and secondary metabolites. Academic Press, Cambridge, UK, 2024, p. 95-104.
[9] A Yang, Y Hong, F Zhou, L Zhang, Y Zhu, C Wang, Y Hu, L Yu, L Chen and X Wang. Endophytic microbes from medicinal plants in Fenghuang mountain as a source of antibiotics. Molecules 2023; 28(17), 6301.
[10] D Handayani, RI Muslim, N Syafni, MA Artasasta and R Riga. Endophytic fungi from medicinal plant Garcinia cowa Roxb. ex Choisy and their antibacterial activity. Journal of Applied Pharmaceutical Science 2024; 14(9), 182-188.
[11] N Sandrawati, SP Hati, F Yunita, AE Putra, F Ismed, TE Tallei, T Hertiani and D Handayani. Antimicrobial and cytotoxic activities of marine sponge-derived fungal extracts isolated from Dactylospongia sp. Journal of Applied Pharmaceutical Science 2020; 10(4), 028-033.
[12] J Mani, J Johnson, H Hosking, BE Hoyos, KB Walsh, P Neilsen and M Naiker. Bioassay-guided fractionation protocol for determining novel active compounds in selected Australian flora. Plants 2022; 11(21), 2886.
[13] B Meyer, N Ferrigni, J Putnam, L Jacobsen, D Nichols and J McLaughlin. Brine shrimp: A convenient general bioassay for active plant constituents. Planta Medica 1982; 45(5), 31-34.
[14] P Kumar, A Nagarajan and PD Uchil. Analysis of cell viability by the MTT assay. Cold Spring Harbor Protocols 2018; 2018(6), 469-471.
[15] JV Meerloo, GJL Kaspers and J Cloos. Cell sensitivity assays: The MTT assay. In: IA Cree (Ed.). Cancer cell culture. Humana press, New Jersey, USA, 2011, p. 237-245.
[16] D Handayani, W Rasyid, EN Zainudin and T Hertiani. Cytotoxic activity screening of fungal extracts derived from the West Sumatran marine sponge Haliclona fascigera to several human cell lines: HeLa, WiDr, T47D, and Vero. Journal of Applied Pharmaceutical Science 2018; 8, 055-058.
[17] GS Guide, MassLynx 4.1, Available at: http://argenta2.chem.unr.edu/downloads/LCMS%20Waters %20MassLynx4.1%20 Manual.pdf, accessed January 2025.
[18] W Zhang, X Li, X Ji and M Gouda. Use of LC-Q-TOF-MS for elucidating the flavonoids. In: M Gouda, X Li and Y He (Eds.). Plant chemical compositions and bioactivities. Humana Press, New York, 2024, p. 165-191.
[19] W Li, J Zhang and LS Francis. Handbook of LC-MS bioanalysis: Best practices, experimental protocols, and regulations. Wiley, New Jersey, USA, 2013, p. 704.
[20] B Zhou, JF Xiao, L Tuli and HW Ressom. LC-MS-based metabolomics. Molecular BioSystems 2012; 8(2), 470-481.
[21] TE Tallei and BJ Kolondam. DNA barcoding of Sangihe Nutmeg (Myristica fragrans) using matK gene. HAYATI Journal of Biosciences 2015; 22(1), 41-47.
[22] K Tamura, G Stecher and S Kumar. MEGA11: Molecular evolutionary genetics analysis version 11. Molecular Biology and Evolution 2021; 38(7), 3022-3027.
[23] RW Birkinshaw, J Gong, CS Luo, D Lio, CA White, MA Anderson, P Blombery, G Lessene, IJ Majewski, R Thijssen, AW Roberts, DCS Huang, PM Colman and PE Czabotar. Structures of BCL-2 in complex with venetoclax reveal the molecular basis of resistance mutations. Nature Communications 2019; 10(1), 2385.
[24] RCSB PDB - 6O0K, Crystal structure of BCL-2 with venetoclax, Available at: https://www.rcsb.org/structure/6O0K, accessed June 2025.
[25] RCSB PDB - 6Q9N, Crystal structure of PBP2a from MRSA in complex with piperacillin and quinazolinone, Available at: https://www.rcsb.org/structure/6Q9N, accessed June 2025.
[26] J Janardhanan, R Bouley, S Martínez-Caballero, Z Peng, M Batuecas-Mordillo, JE Meisel, D Ding, VA Schroeder, WR Wolter, KV Mahasenan, JA Hermoso, S Mobashery and M Chang. The quinazolinone allosteric inhibitor of PBP 2a synergizes with piperacillin and tazobactam against methicillin-resistant staphylococcus aureus. Antimicrobial Agents and Chemotherapy 2019; 63(5), e02637.
[27] MC Nagtilak. Molecular docking: A highly efficient method for structure-based drug designing. In: VA Chavan, PS Sagar, R Shukla, E Laxminarayana, A Debnath, S Supriya, U Das and S Vijayakumar (Eds.). Futuristic trends in chemical material sciences & nano technology. Iterative International Publishers, Michigan, USA, 2024, p. 97-106.
[28] Molecular Docking With Molecular Operating Environment (MOE), Available at: https://www.chemcomp.com/ moe/help/latest/index_tut.html, accessed November 2024.
[29] BD Systèmes. Discovery Studio Visualizer Software. Accelrys, San Diego, 2021.
[30] E Udayan and JJ Gnanadoss. Potential of endophytic fungi as therapeutics: Antibiotics, antiviral and anticancer properties. Research Journal of Biotechnology 2023; 18(6), 132-145.
[31] SK Deshmukh, L Dufossé, H Chhipa, S Saxena, GB Mahajan and MK Gupta. Fungal endophytes: A Potential source of antibacterial compounds. Journal of Fungi 2022; 8(2), 164.
[32] SJ Li, X Zhang, XH Wang and CQ Zhao. Novel natural compounds from endophytic fungi with anticancer activity. European Journal of Medicinal Chemistry 2018; 156, 316-343.
[33] D Handayani, MA Artasasta, D Mutia, N Atikah, Rustini and TE Tallei. Antimicrobial and cytotoxic activities screening of fungal secondary metabolites isolated from marine sponge Callyspongia sp. AACL Bioflux 2021; 14(1), 249-258.
[34] MA Artasasta, Y Yanwirasti, M Taher, A Djamaan, NP Ariantari, RA Edrada-Ebel and D Handayani. Apoptotic activity of new oxisterigmatocystin derivatives from the marine-derived fungus Aspergillus nomius NC06. Marine Drugs 2021; 19(11), 631.
[35] Aspergillus terreus, Doctor Fungus, Available at: https://drfungus.org/knowledge-base/aspergillus-terreus/, accessed June 2025.
[36] C Lass-Flörl, AM Dietl, DP Kontoyiannis and M Brock. Aspergillus terreus species complex. Clinical Microbiology Reviews 2021; 34(4), e0031120.
[37] P Kapli, Z Yang and MJ Telford. Phylogenetic tree building in the genomic age. Nature Reviews Genetics 2020; 21(7), 428-444.
[38] MS Lestari, T Himawan, AL Abadi and R Retnowati. Toxicity and phytochemistry test of methanol extract of several plants from papua using Brine Shrimp Lethality Test (BSLT). Journal of Chemical and Pharmaceutical Research 2015; 7(4), 866-872.
[39] H Niksic, F Becic, E Koric, I Gusic, E Omeragic, S Muratovic, B Miladinovic and K Duric. Cytotoxicity screening of Thymus vulgaris L. essential oil in brine shrimp nauplii and cancer cell lines. Scientific Reports 2021; 11(1), 13178.
[40] S Ghosal, K Biswas and DK Chakrabarti. Toxic naphtho-.gamma.-pyrones from Aspergillus niger, Journal of Agricultural and Food Chemistry 1979; 27(6), 1347-1351.
[41] S Padhi, M Masi, SK Panda, W Luyten, A Cimmino, K Tayung and A Evidente. Evidente, antimicrobial secondary metabolites of an endolichenic Aspergillus niger isolated from lichen thallus of Parmotrema ravum. Natural Product Research 2020; 34(18), 2573-2580.
[42] Dulcioic acid | C7H12O8, Available at: https://www.chemspider.com/Chemical-Structure.29365152.html, accessed July 2025.
[43] 8-Benzyl-3-(4-biphenylyl)-4,9-dimethyl-7H-furo[2,3-f]chromen-7-one,C32H24O3, https://www.chemspider.com/Chemical-Structure.1385615.html, accessed July 2025.
[44] PubChem, Malformin A, Available at: https://pubchem.ncbi.nlm.nih.gov/compound/4005, accessed June 2025.
[45] PubChem, Aurasperone B, Available at: https://pubchem.ncbi.nlm.nih.gov/compound/179522, accessed June 2025).
[46] PubChem, Fonsecinone B, Available at: https://pubchem.ncbi.nlm.nih.gov/compound/101301306, accessed June 2025.
[47] Aurasperone A, C32H26O10, Available at: https://www.chemspider.com/Chemical-Structure.2341316.html, accessed July 2025.
[48] K Palaniveloo, KH Ong, H Satriawan, SA Razak, S Suciati, HY Hung, S Hirayama, M Rizman-Idid, JK Tan, YS Yong and SM Phang. In vitro and in silico cholinesterase inhibitory potential of metabolites from Laurencia snackeyi (Weber-van Bosse) M. Masuda. 3 Biotech 2023; 13(10), 337.
[49] SA Attique, M Hassan, M Usman, RM Atif, S Mahboob, KA Al-Ghanim, M Bilal and MZ Nawaz. A molecular d ocking approach to evaluate the pharmacological properties of natural and synthetic treatment candidates for use against hypertension. International Journal of Environmental Research and Public Health 2019; 16(6), 923.
[50] H Purnomo. Kimia Komputasi: Molecular docking plants-penambatan molekul plants (protein ligand ant system). Pustaka Pelajar, Yogyakarta, 2011.
[51] S Mukherjee, TE Balius and RC Rizzo. Docking validation resources: Protein family and ligand flexibility experiments. Journal of Chemical Information and Modeling 2010; 50(11), 1986-2000.